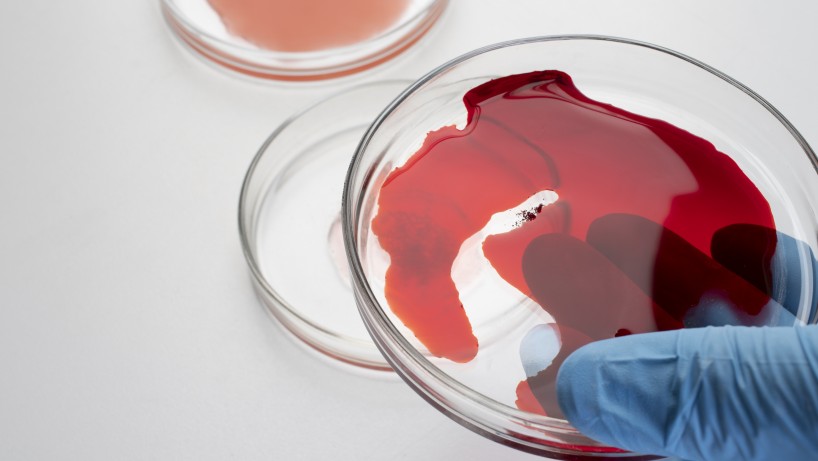

Загальний аналіз крові (автоматизований підрахунок на гематологічному аналізаторі, 25 показників, без ШОЕ)
250,00 грн.| Термін | Один день |
|---|
Загальний аналіз крові (ОАК) – це одне з найпоширеніших та інформативних лабораторних досліджень, що дозволяє оцінити загальний стан організму та роботу кровотворної системи. Аналіз допомагає виявити запальні та інфекційні процеси, анемію, порушення імунітету, проблеми зі згортанням крові та низку інших захворювань навіть на ранніх стадіях.
Загальний аналіз крові є одним із найбільш інформативних та доступних методів діагностики, що дозволяють оцінити загальний стан організму та виявити різні порушення на ранніх стадіях. Серед безлічі показників особливе значення має MCV (mean corpuscular volume) – середній об’єм еритроцитів. Цей параметр допомагає лікарю визначити особливості кровотворення, виявити тип анемії та запідозрити низку патологічних процесів.
Зміни MCV можуть бути як тимчасовими і незначними, так і свідчити про серйозні порушення, тому правильна інтерпретація цього показника завжди проводиться в комплексі з іншими лабораторними даними та клінічними симптомами.
Що таке MCV (середній об’єм еритроцитів)
MCV – це показник, що відображає середній розмір еритроцитів, тобто червоних кров’яних клітин, які виконують найважливішу функцію транспортування кисню до тканин та органів. Він вимірюється у фемтолітрах і визначається автоматично при виконанні загального аналізу крові з використанням гематологічних аналізаторів.
Розмір еритроцитів має велике значення для їх функціональності. Занадто маленькі клітини можуть переносити менше кисню, а занадто великі – бути менш стійкими та швидше руйнуватися. Таким чином, MCV є непрямим індикатором ефективності кровотворення та стану обмінних процесів в організмі.
Роль середнього об’єму еритроцитів у діагностиці захворювань крові
Показник середнього об’єму еритроцитів широко використовується в клінічній практиці для діагностики різних захворювань крові, насамперед анемій. Він дозволяє лікарю не лише зафіксувати наявність проблеми, але й визначити її можливу природу.
У поєднанні з іншими показниками, такими як рівень гемоглобіну, гематокрит та кількість еритроцитів, MCV допомагає:
- класифікувати анемію
- виявити дефіцит заліза або вітамінів
- оцінити стан кісткового мозку
- запідозрити хронічні запальні або системні захворювання
Особливо важливий цей показник при диференціальній діагностиці, коли симптоми можуть бути схожими, а причини – різними.
Норма MCV у дорослих та дітей
Нормальні значення MCV залежать від віку пацієнта та фізіологічних особливостей організму. У дорослих показник зазвичай знаходиться в межах 80–100 фл, що вважається оптимальним діапазоном для нормального функціонування еритроцитів.
У дітей норми можуть відрізнятися, особливо в ранньому віці. Наприклад, у новонароджених еритроцити більші, тому MCV вищий, а потім поступово знижується до значень, характерних для дорослих.
Важливо враховувати, що незначні відхилення від норми не завжди свідчать про патологію. Оцінка результатів повинна проводитися лікарем з урахуванням загального стану пацієнта, скарг та інших лабораторних даних.
Знижений середній об’єм еритроцитів: причини та значення
Зниження середнього об’єму еритроцитів називається мікроцитозом і вказує на зменшення розміру еритроцитів. Цей стан найчастіше пов’язаний із порушенням синтезу гемоглобіну, який відіграє ключову роль у структурі червоних кров’яних клітин.
Найпоширенішою причиною є дефіцит заліза, який може розвиватися через недостатнє надходження з їжею, хронічні крововтрати або порушення всмоктування. Також мікроцитоз може спостерігатися при деяких спадкових захворюваннях крові та хронічних запальних процесах.
Знижений MCV потребує додаткового обстеження, оскільки без виявлення причини та її усунення стан може прогресувати та призводити до вираженої анемії.
Підвищений середній об’єм еритроцитів: причини та можливі захворювання
Підвищення MCV (макроцитоз) свідчить про збільшення розміру еритроцитів. Це може відбуватися при порушенні процесів їх дозрівання в кістковому мозку.
Однією з найчастіших причин є дефіцит вітаміну B12 та фолієвої кислоти, які необхідні для нормального поділу клітин. Також макроцитоз може спостерігатися при захворюваннях печінки, зловживанні алкоголем та деяких ендокринних порушеннях.
В окремих випадках підвищення MCV пов’язане з прийомом лікарських препаратів або є тимчасовим станом. Тим не менш, при виявленні такого відхилення важливо провести додаткову діагностику.
Середній об’єм еритроцитів і анемія: як пов’язані показники
MCV відіграє ключову роль у класифікації анемій, дозволяючи розділити їх на кілька типів залежно від розміру еритроцитів. Це значно спрощує діагностику та допомагає швидше визначити причину захворювання.
Виділяють три основні варіанти:
- мікроцитарна анемія – при зниженні MCV
- нормоцитарна – при нормальних значеннях
- макроцитарна – при підвищеному MCV
Такий підхід дозволяє лікарю вибудувати подальший діагностичний алгоритм та призначити необхідні дослідження для уточнення причини.
Симптоми при відхиленнях середнього об’єму еритроцитів
Сам по собі показник MCV не викликає симптомів, однак стани, з якими він пов’язаний, можуть проявлятися різними ознаками. Найчастіше пацієнти скаржаться на слабкість, підвищену втомлюваність, запаморочення та зниження працездатності.
При виражених порушеннях можуть з’являтися:
- блідість шкіри
- задишка при навантаженні
- прискорене серцебиття
- зниження концентрації уваги
Ці симптоми потребують звернення до лікаря та проведення обстеження.
Діагностика: як визначається MCV в аналізі крові
MCV визначається в рамках загального аналізу крові, який є стандартним лабораторним дослідженням. Для цього використовується венозна або капілярна кров, а розрахунок показника здійснюється автоматично.
Додатково лікар може призначити розширені дослідження, включаючи визначення рівня заліза, феритину, вітаміну B12 та інших показників. У медичному центрі «Альтернатива» проводиться комплексна діагностика, що дозволяє точно оцінити стан пацієнта.
Підготовка до здачі загального аналізу крові
Для отримання достовірних результатів важливо правильно підготуватися до дослідження. Рекомендується здавати кров вранці натщесерце, уникати інтенсивних фізичних навантажень та стресів напередодні.
Також слід:
- виключити алкоголь за добу
- не вживати жирну їжу перед аналізом
- за можливості узгодити прийом ліків з лікарем
Дотримання цих рекомендацій допомагає мінімізувати вплив зовнішніх факторів на результат.
Коли середній об’єм еритроцитів змінюється без виражених симптомів
У низці випадків зміни MCV можуть перебігати безсимптомно, особливо на ранніх стадіях захворювань. Організм здатен компенсувати порушення, тому людина може не відчувати явних проблем.
Саме тому профілактичні обстеження відіграють важливу роль. Регулярний контроль показників крові дозволяє виявити відхилення до появи клінічних проявів.
Лікування при порушеннях середнього об’єму еритроцитів
Лікування спрямоване на усунення причини зміни показника. Це може включати корекцію дефіцитів, лікування хронічних захворювань або зміну способу життя.
Залежно від ситуації застосовуються:
- препарати заліза
- вітамінні комплекси
- терапія основного захворювання
- спостереження в динаміці
Підбір лікування здійснюється індивідуально лікарем.
Харчування та спосіб життя для нормалізації показника
Раціон харчування суттєво впливає на показники крові. Для підтримання нормального рівня MCV важливо забезпечити надходження необхідних мікроелементів та вітамінів.
Рекомендується включати:
- продукти, багаті на залізо
- джерела вітаміну B12
- продукти з фолієвою кислотою
Також важливо дотримуватися режиму сну, підтримувати фізичну активність та уникати шкідливих звичок.
Коли необхідно звернутися до лікаря
Звернутися до фахівця слід при виявленні відхилень в аналізах або появі симптомів, таких як слабкість, запаморочення та швидка втомлюваність.
Своєчасне звернення дозволяє:
- встановити причину порушень
- розпочати лікування на ранній стадії
- запобігти розвитку ускладнень
Профілактика порушень крові та анемії
Профілактика включає регулярні медичні обстеження, збалансоване харчування та контроль хронічних захворювань.
У медичному центрі «Альтернатива» проводиться комплексна діагностика, що дозволяє виявляти порушення показників крові на ранніх етапах та своєчасно вживати заходів.
Часті запитання про середній об’єм еритроцитів та аналіз крові
- Що показує MCV в аналізі крові? MCV показує середній об’єм еритроцитів, тобто їх розмір. Цей показник допомагає оцінити стан кровотворення та використовується для діагностики різних видів анемії.
- Що означає знижений MCV в аналізі крові? Знижений MCV в аналізі крові вказує на зменшений розмір еритроцитів і найчастіше пов’язаний з дефіцитом заліза або хронічними крововтратами.
- Що означає підвищений MCV в аналізі крові? Підвищений MCV в аналізі крові свідчить про збільшення розміру еритроцитів. Це може бути пов’язано з дефіцитом вітаміну B12, фолієвої кислоти або захворюваннями печінки.
- Чи можна за одним MCV поставити діагноз? Ні, MCV – це лише один із показників аналізу крові. Для постановки діагнозу лікар оцінює його разом з іншими параметрами та клінічною картиною.
- Як часто потрібно здавати аналіз крові на MCV? Частота здачі аналізу крові визначається індивідуально. У профілактичних цілях рекомендується проходити обстеження 1 раз на рік або за призначенням лікаря.
- Чи може MCV бути зміненим без симптомів? Так, зміни MCV в аналізі крові можуть перебігати безсимптомно, особливо на ранніх стадіях. Тому важливі регулярні обстеження.
- Як підготуватися до аналізу крові на MCV? Для точного визначення MCV в аналізі крові рекомендується здавати кров натщесерце, уникати алкоголю та фізичних навантажень напередодні дослідження.
- Коли потрібно звертатися до лікаря при зміні MCV? Звернутися до лікаря необхідно при відхиленнях MCV в аналізі крові, особливо якщо вони супроводжуються слабкістю, запамороченням або іншими симптомами.
MCV є важливим показником загального аналізу крові, що відображає середній розмір еритроцитів та дозволяє оцінити стан кровотворної системи. Його зміна може вказувати на різні патологічні процеси, включаючи анемії та дефіцитні стани.
Регулярний контроль показників крові, уважне ставлення до симптомів та своєчасне звернення до лікаря дозволяють виявити порушення на ранній стадії та провести ефективну корекцію. Комплексний підхід до діагностики та лікування є основою збереження здоров’я та профілактики ускладнень.
Загальний аналіз крові (автоматизований підрахунок на гематологічному аналізаторі, 25 показників, без ШОЕ)
250,00 грн.| Термін | Один день |
|---|
Загальний аналіз крові (ОАК) – це одне з найпоширеніших та інформативних лабораторних досліджень, що дозволяє оцінити загальний стан організму та роботу кровотворної системи. Аналіз допомагає виявити запальні та інфекційні процеси, анемію, порушення імунітету, проблеми зі згортанням крові та низку інших захворювань навіть на ранніх стадіях.